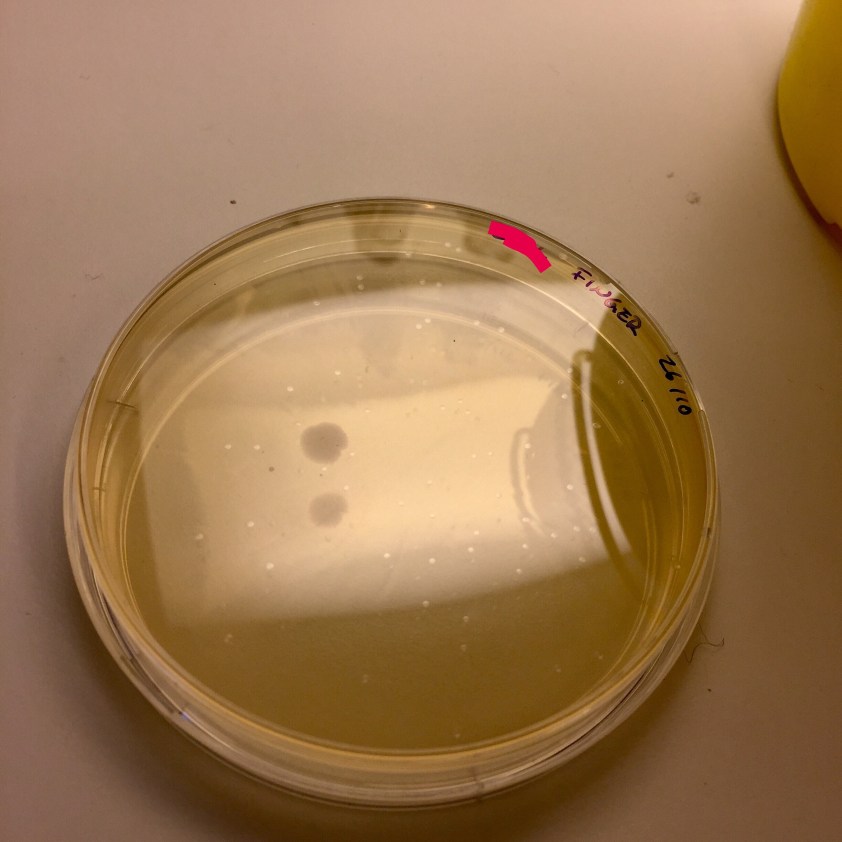
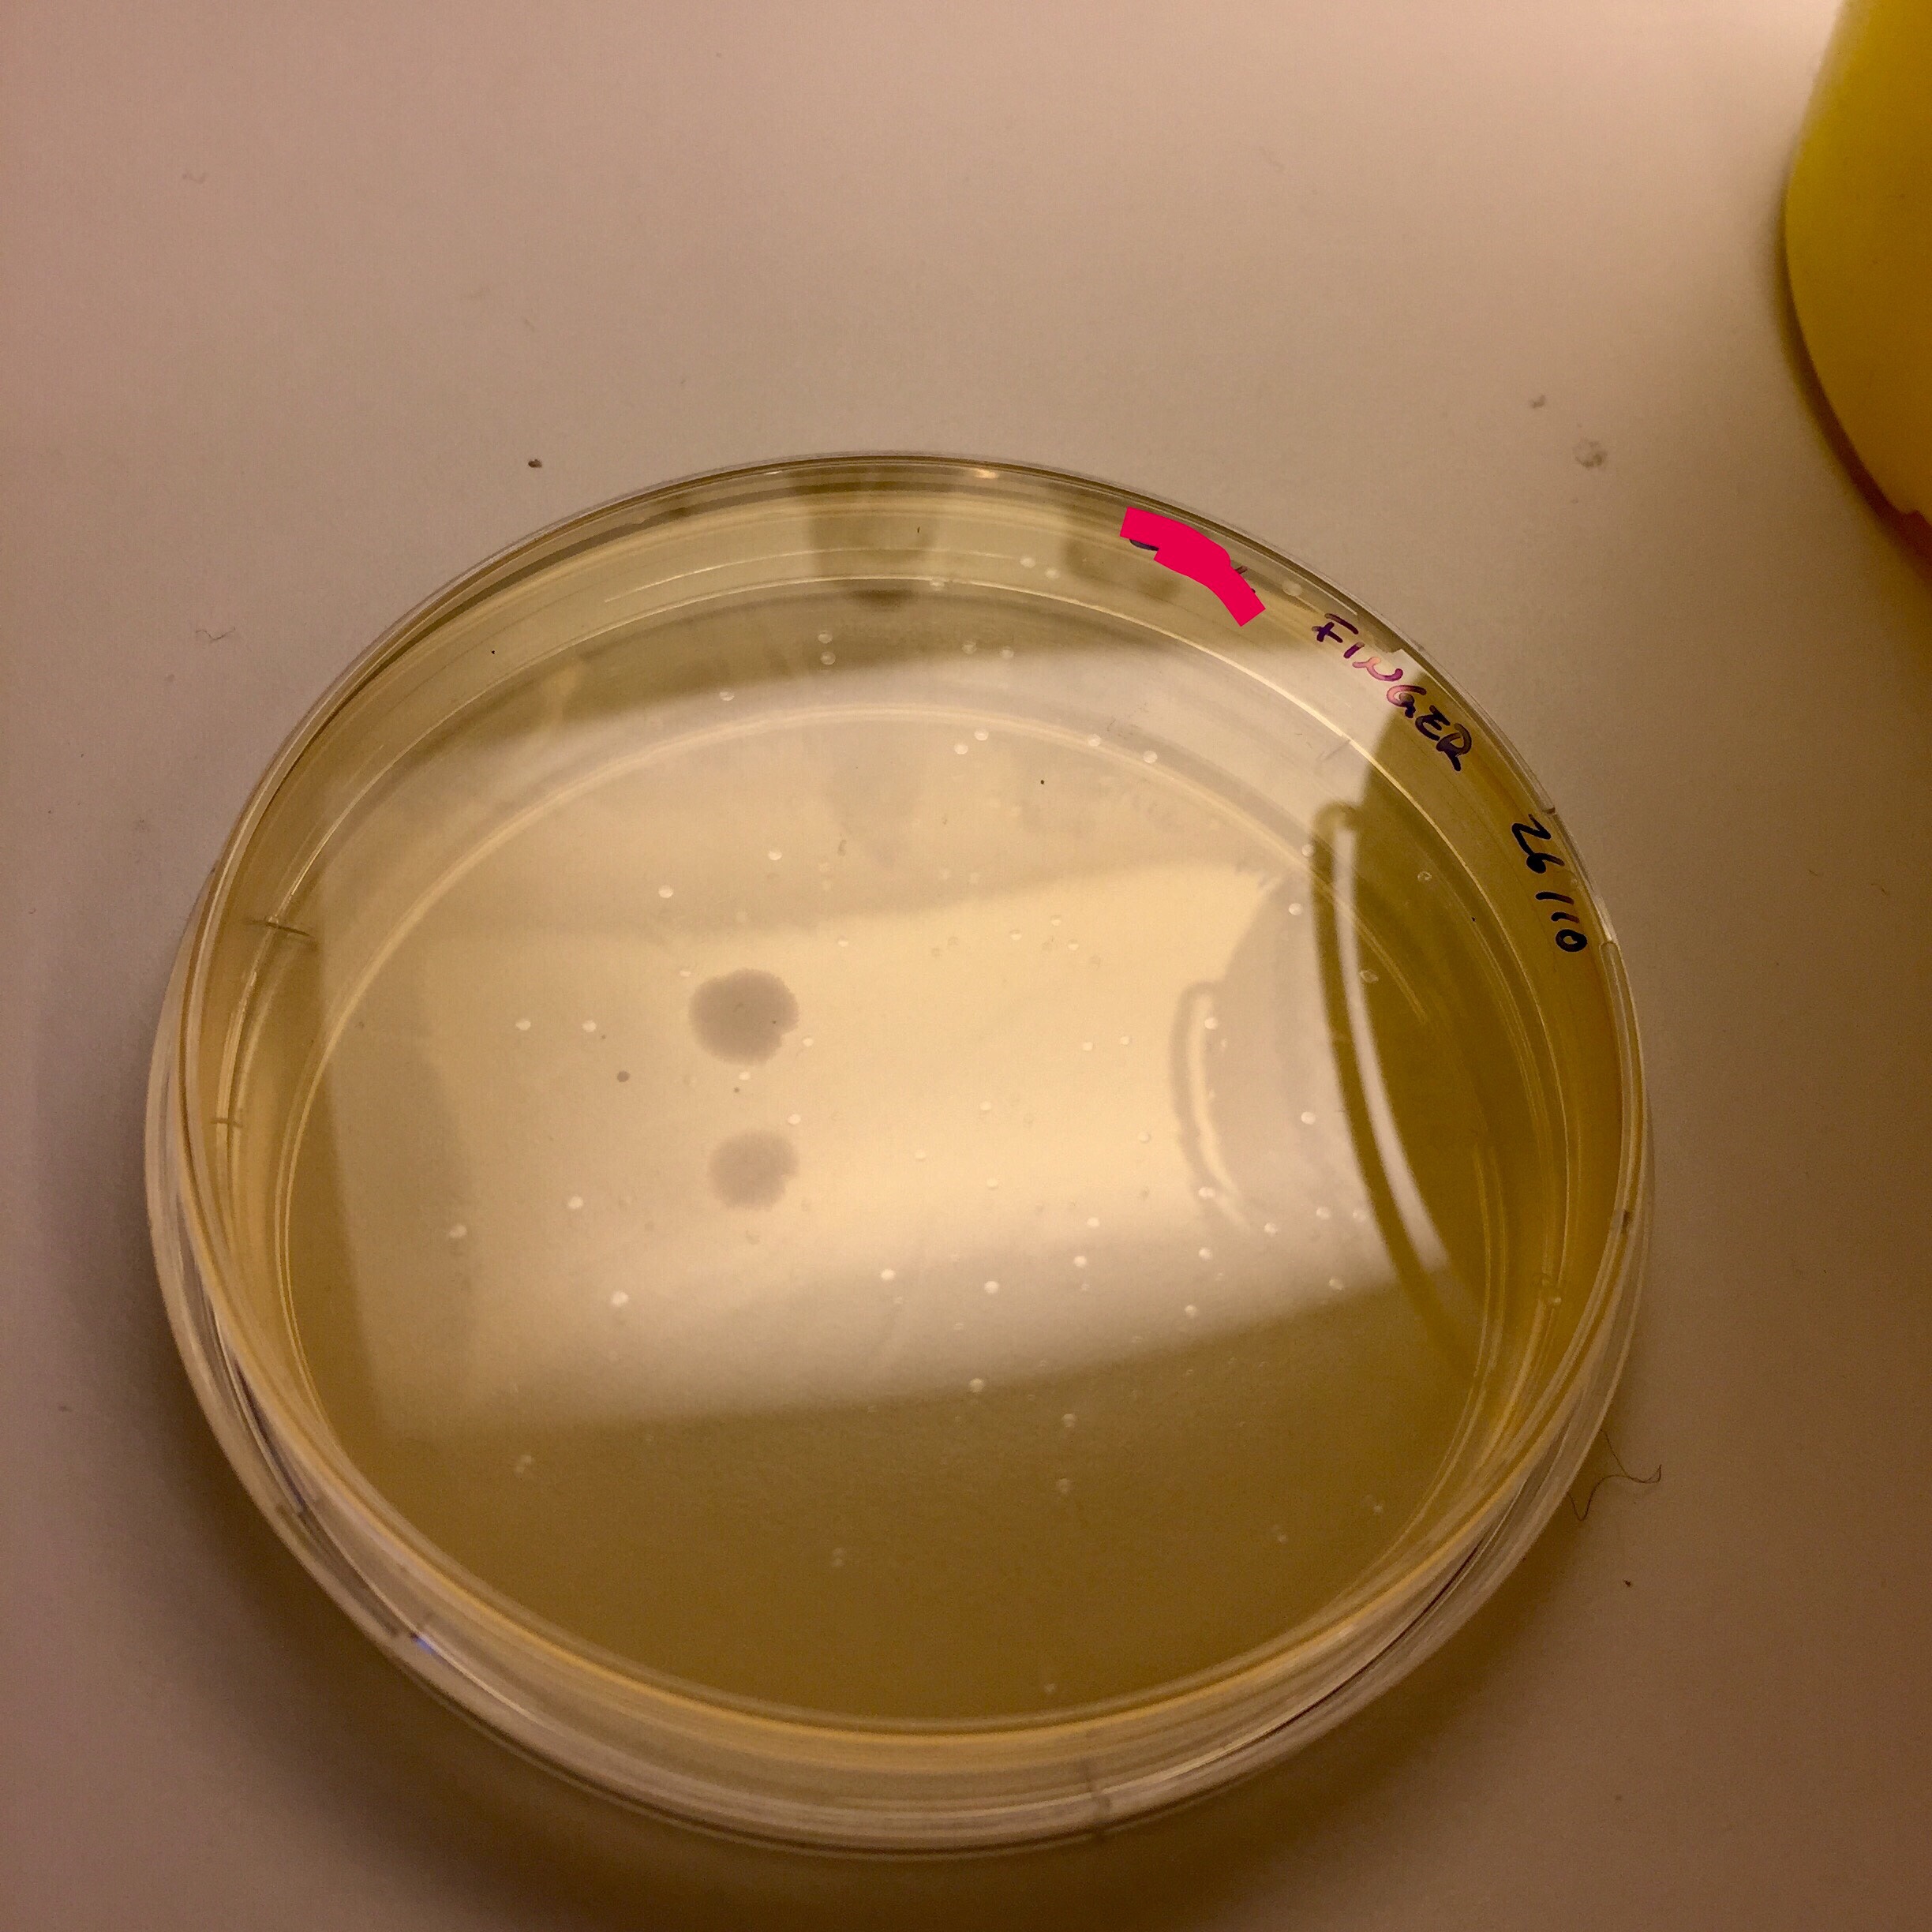
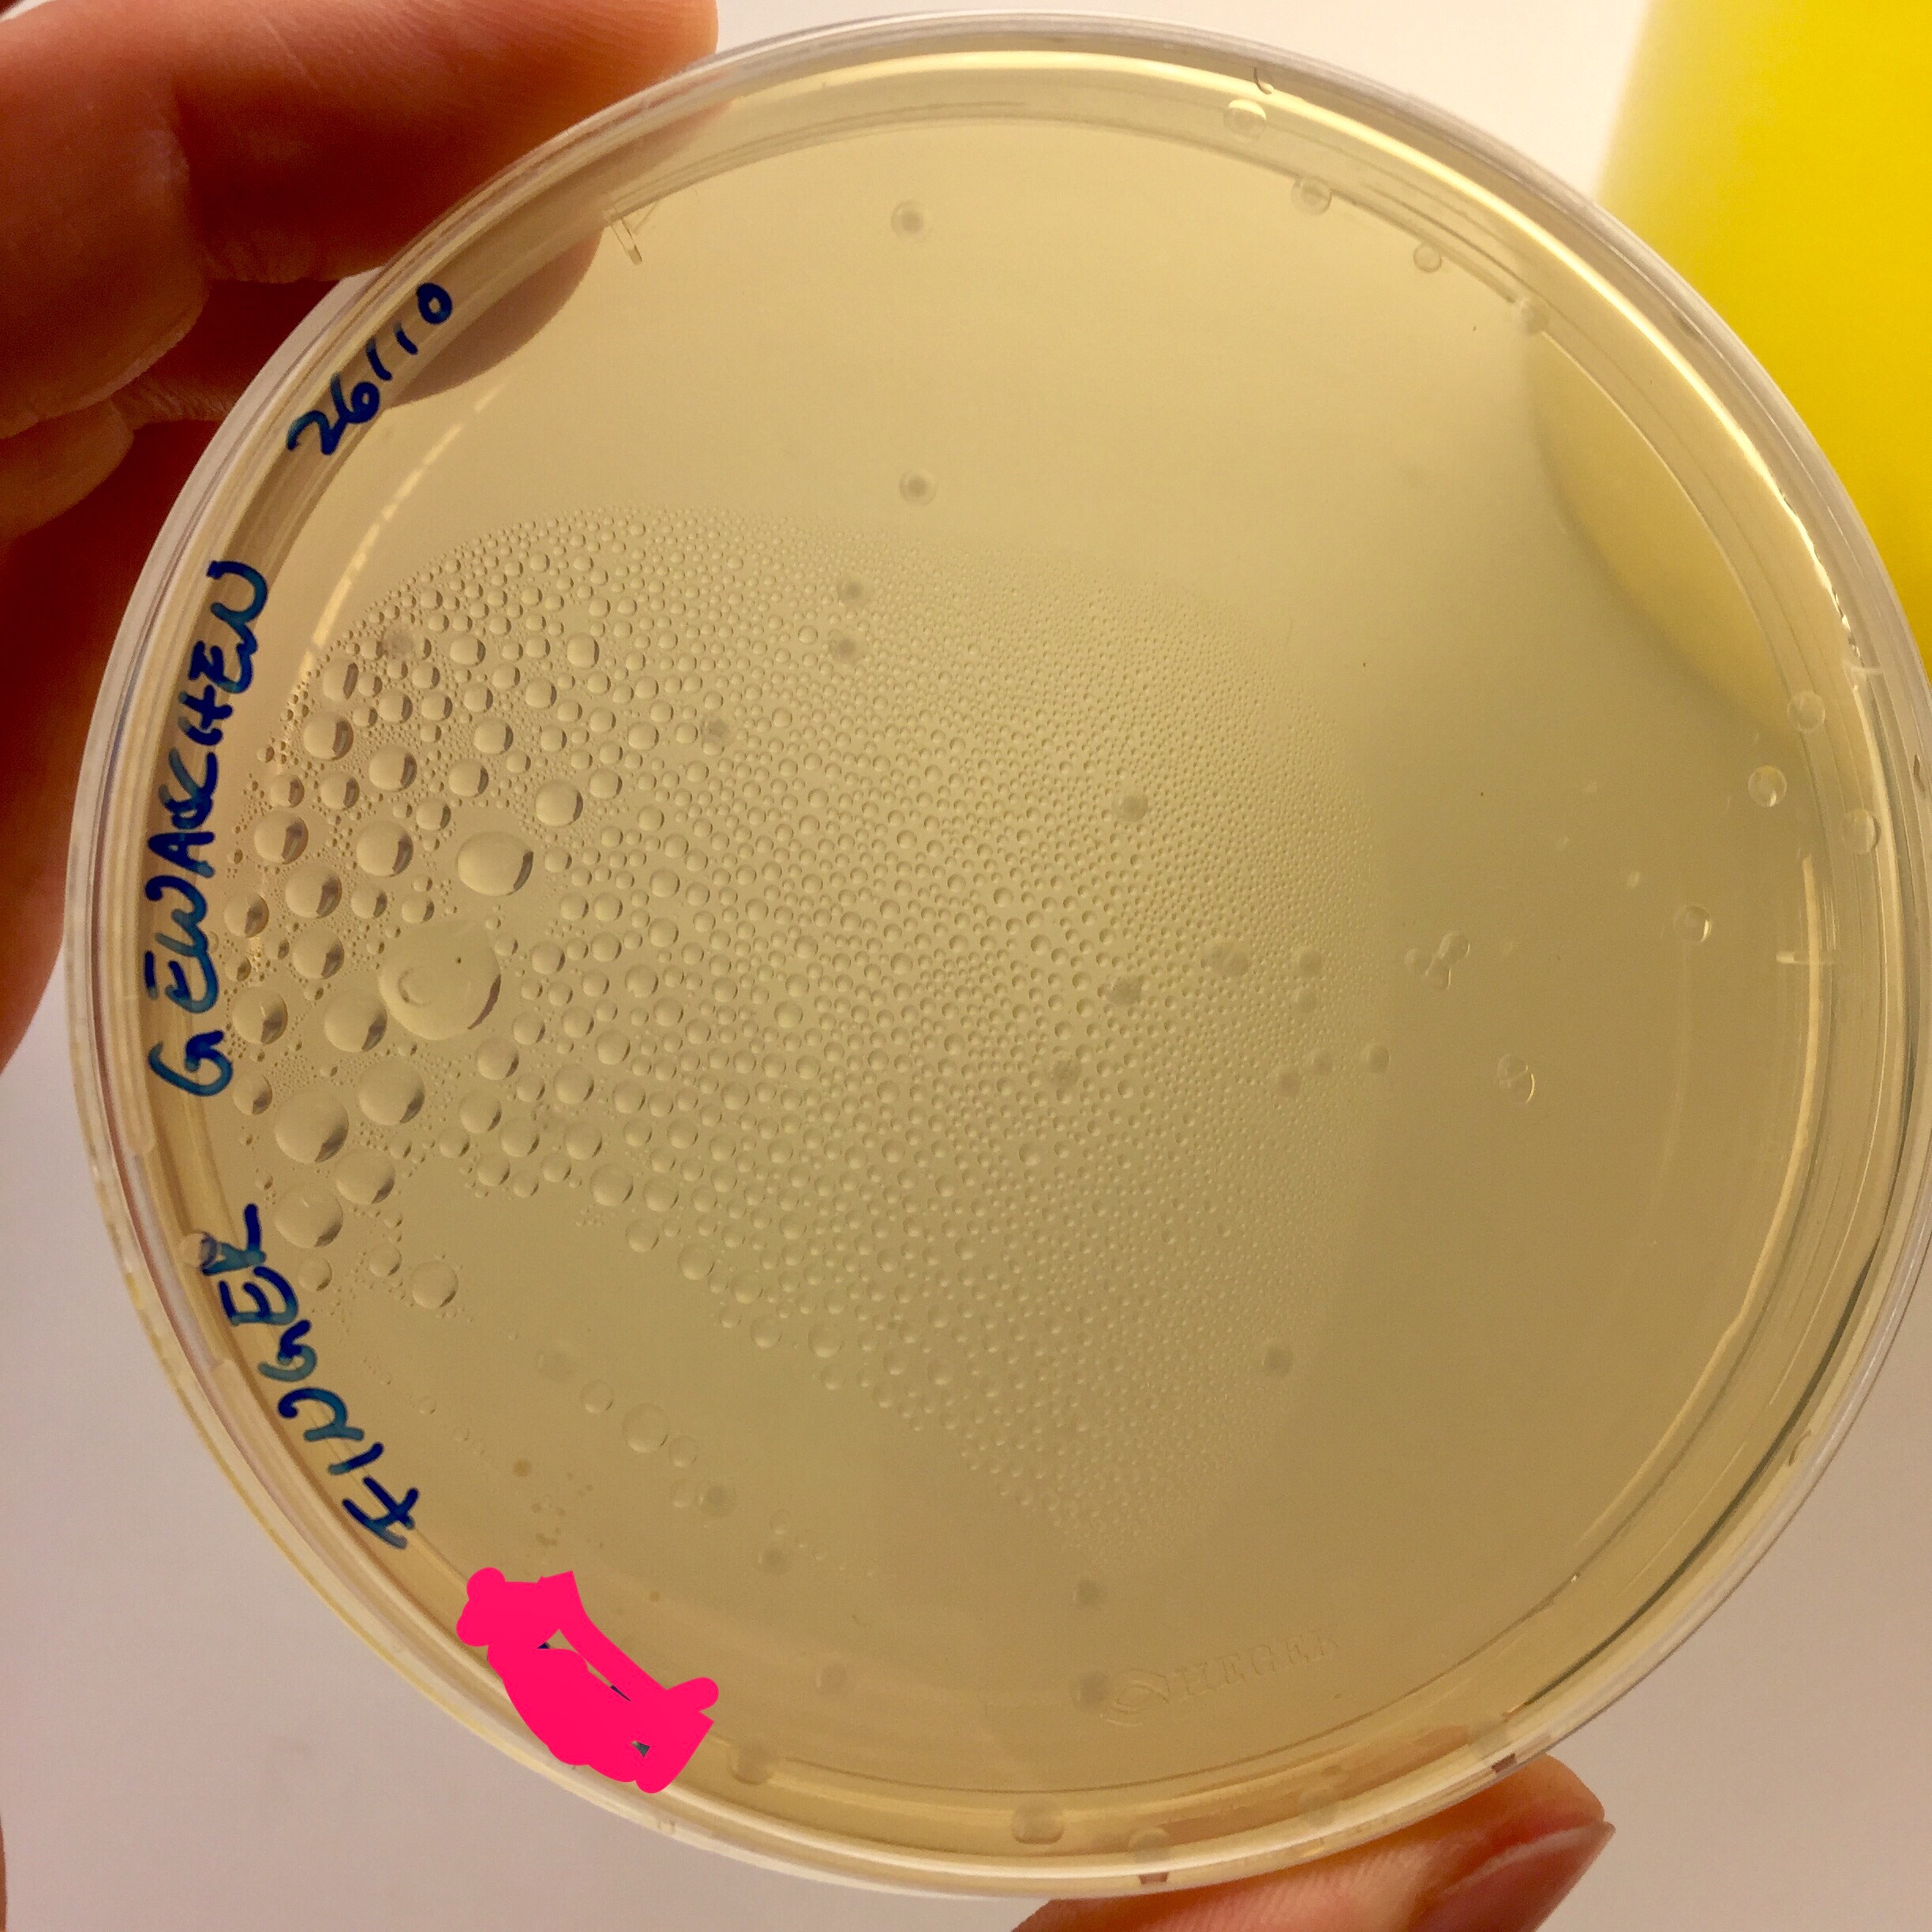
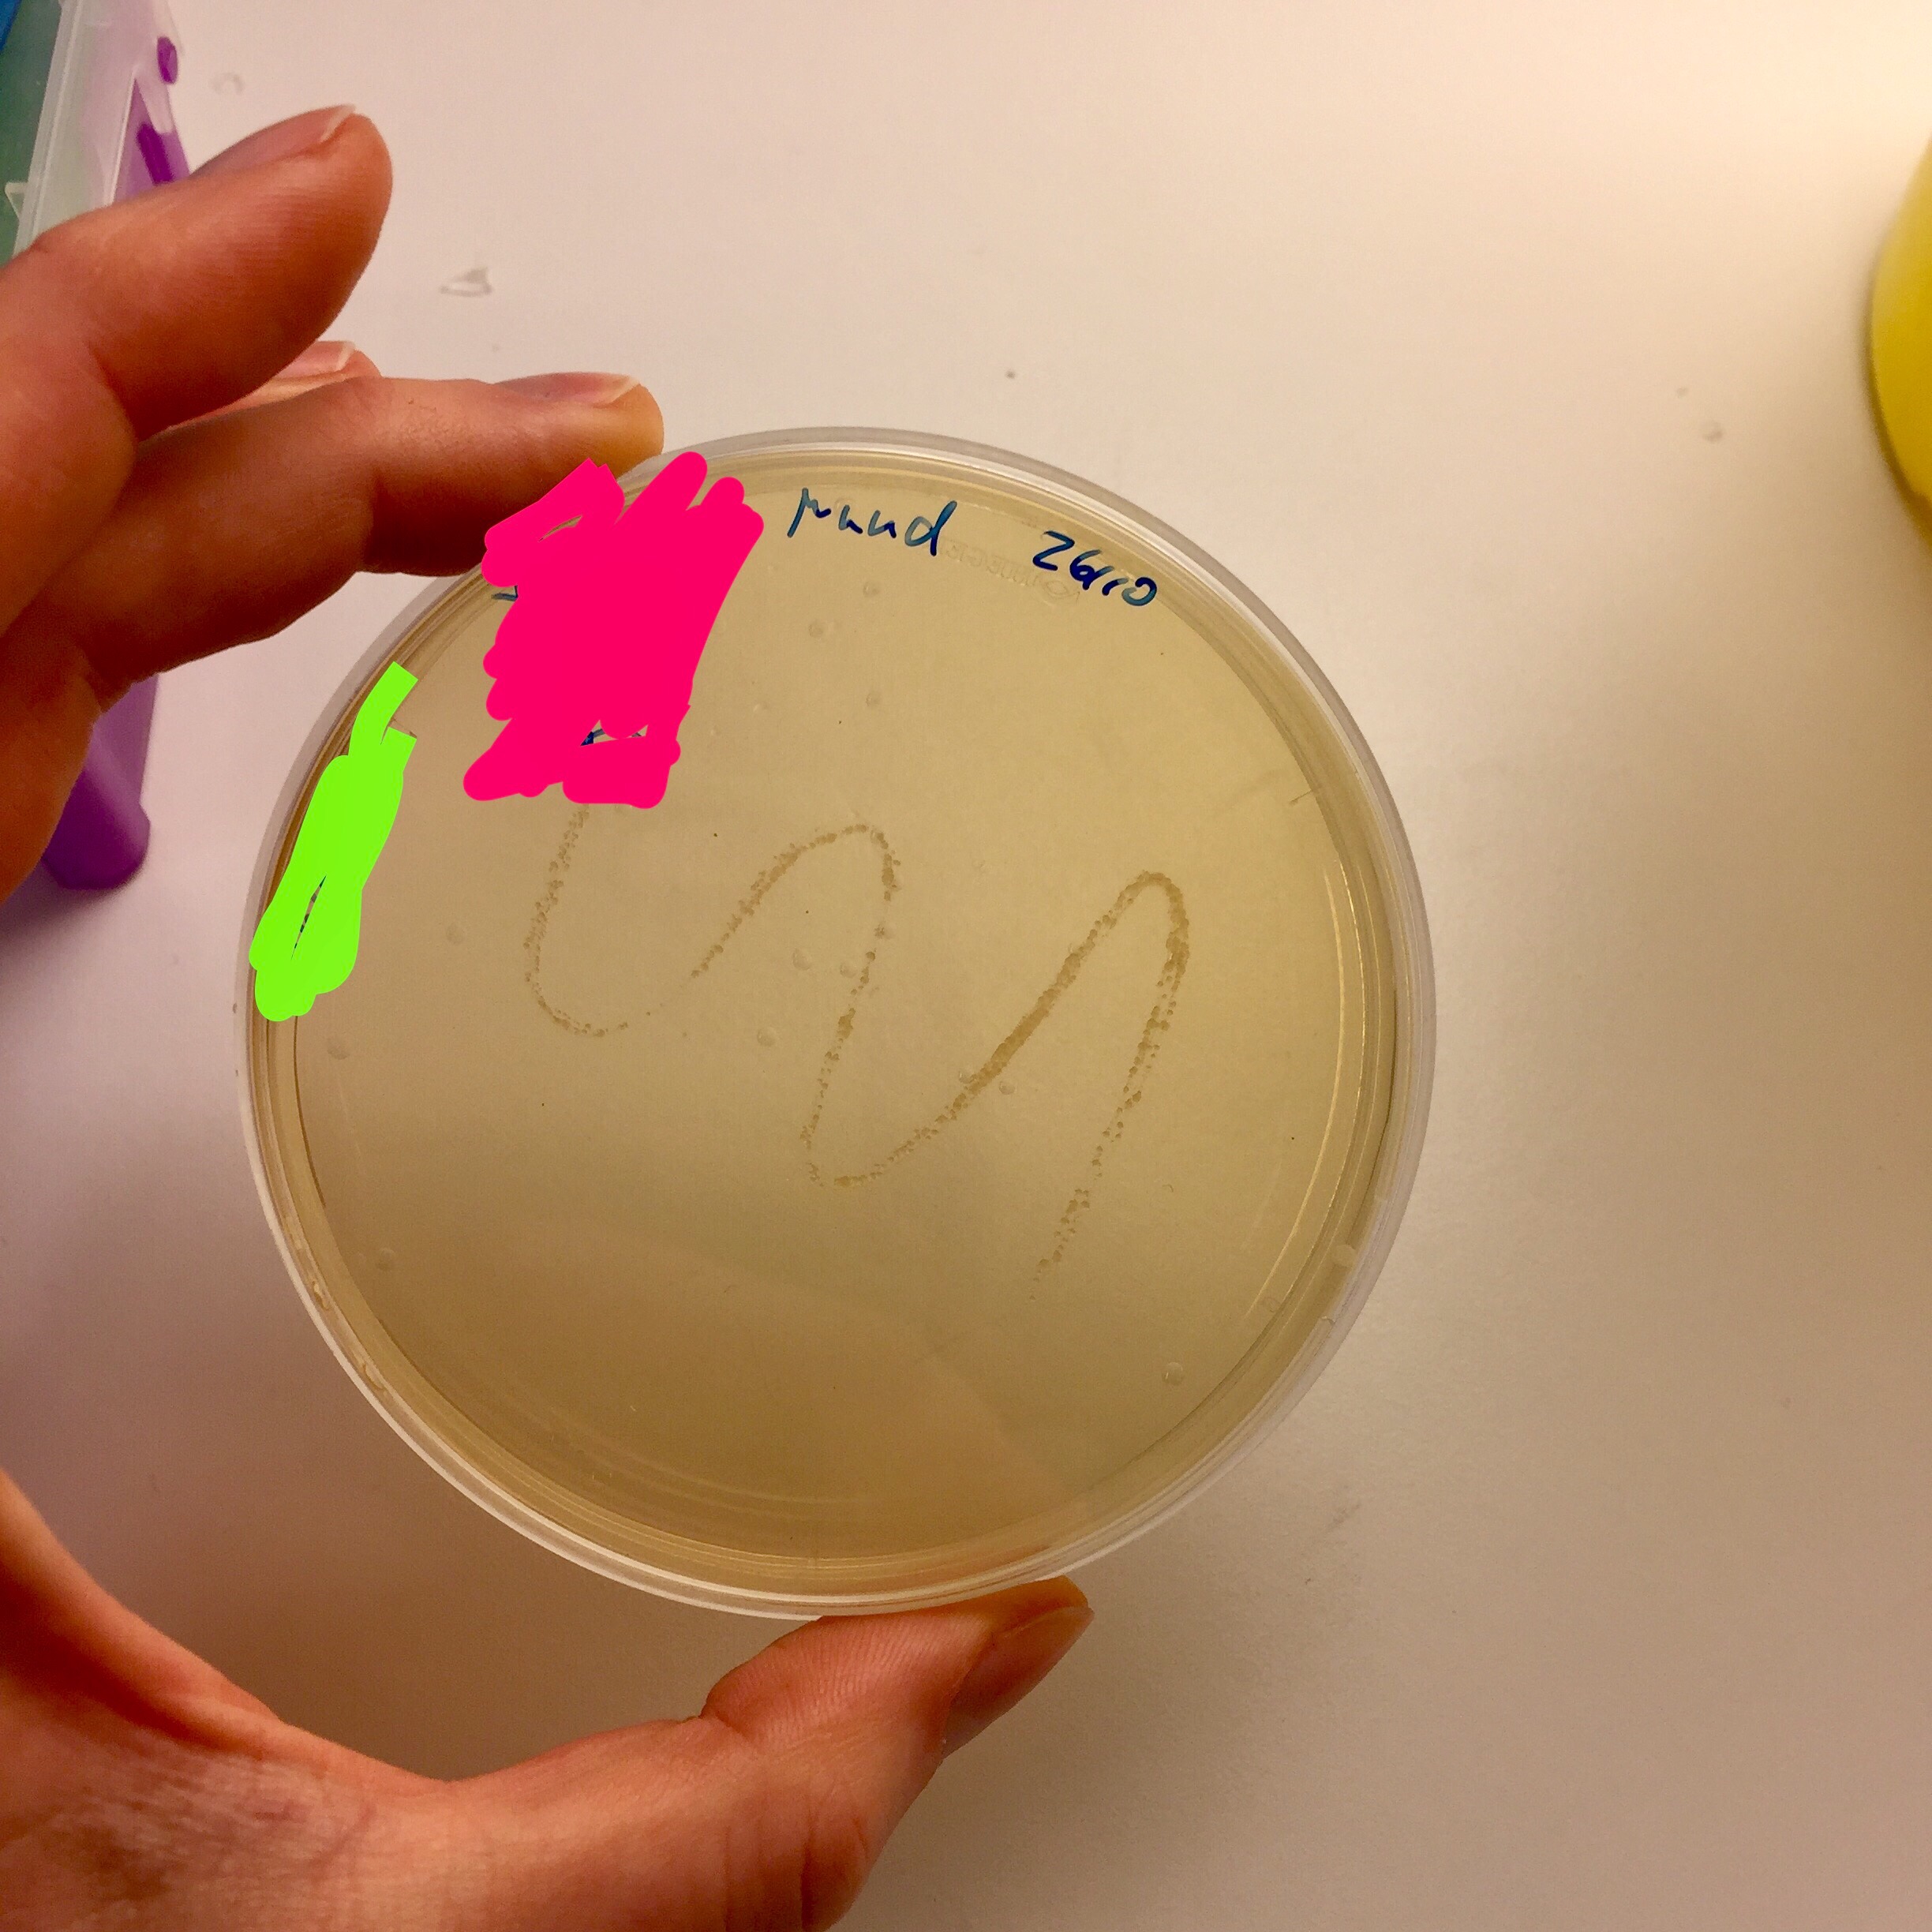
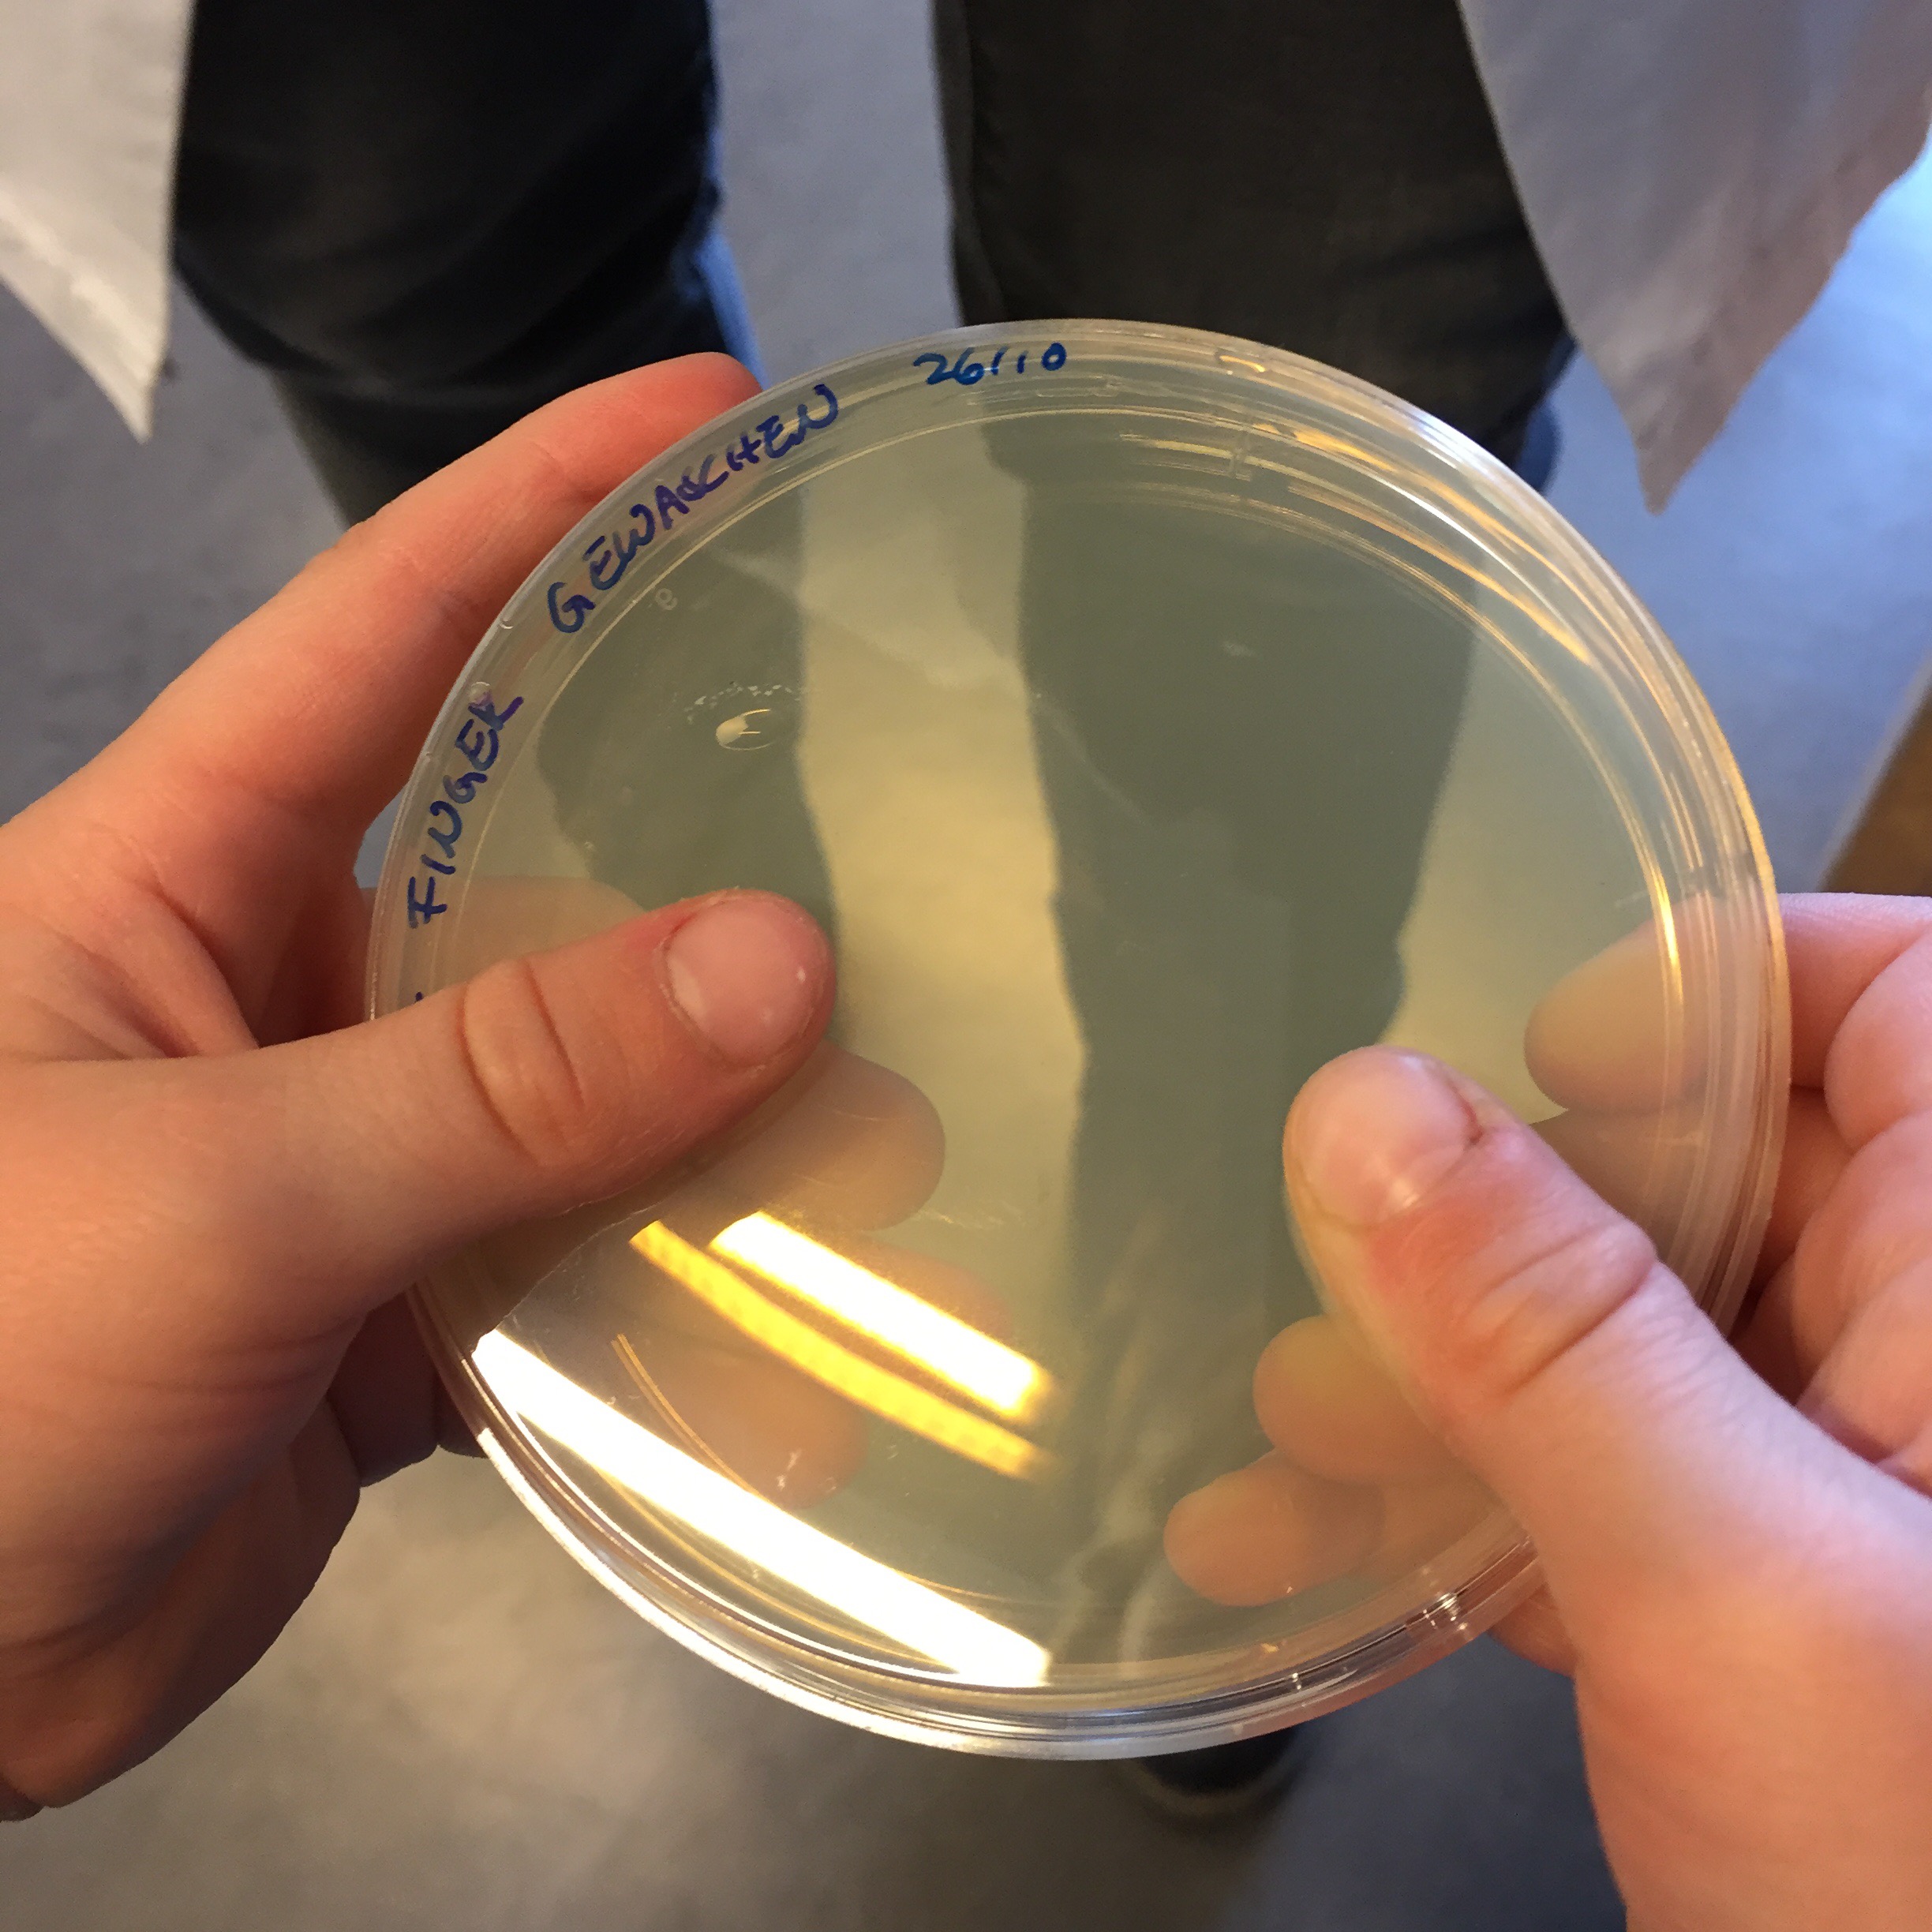

Es war einmal eine Frau, die vergaß völlig, dass sie ja diesen Monat Gastgeberin für die Off-Topic-Runde ist. Als sie drauf aufmerksam gemacht wurde, war es schon zu spät, selbst ein verschobener Veröffentlichungstermin würde die Teilnehmerinnen ganz schön unter Zeitdruck setzen.
Diese Frau war ich. Und deshalb lud ich die Damen zu einer Runde über genau dieses Thema ein: Zeitdruck. Wie gehen sie damit um, wenn die Zeit eng wird? Oder haben sie gar geheime Tipps, wei man gar nicht erst unter Zeitdruck gerät? Dieses mal in meinem Wohnzimmer: Kathrin, snowqueen und Lena!
____
Kathrin (Oekohippierabenmutter)
Wenn morgens der erste kleine Hosenkacker auf meinem Kopf herum krabbelt, schlage ich so langsam die Augen auf. Ich bin immer totmüde, ich stille nachts noch und bin dementsprechend unausgeschlafen. Ich öffne also die Augen und schaue auf die Uhr: 6.30 Uhr. Shit! Sooo späääät?
Wir verbringen den Vormittag draußen, egal bei welchem Wetter. Ohne frische Luft kommen die Jungs mittags nicht zur Ruhe. Ich sehe auf die Uhr. 11.45 Uhr. Verdammt! Soooo späääät?
Ich muss kochen. Es ist 17.00 Uhr. Shit. Zu spät.
Ich wollte doch noch – kacke. Zu spät. Und da war doch noch – egal. Jetzt ist es zu spät.
Mein ganzes Leben ist ein einziger Zeitdruck, zumindest fühlt es sich so an. Woher kommt das? Die Zeit ist das einzige, was nie anhält, die nie mehr wird und die wir einfach nicht beeinflussen können, egal wie wir sie verbringen. Wenn ich also unter Zeitdruck Hetze und Hektik verbreite, dann läuft sie ganz genau so schnell ab, wie wenn ich die Dinge, die ich tun muss, langsam tue. Ich stehe immer zeitlich unter Druck. Also wie gehe ich damit um?
Tja. Gar nicht. Uhren trage ich nicht. In meiner Wohnung gibt es keine. Die an meinem Handy reicht und stresst mich genug. Dinge bleiben liegen, stressen mich trotzdem. An der Zeit kann ich nicht drehen, das habe ich verstanden. Aber beherrschen muss sie mich ja nun auch nicht.
Also stehe ich um 6.30 Uhr auf, trinke meine zwei Kaffee und daddel zu lang am Handy rum. Dusche zu lang. Frühstücke zu lang mit meinen Jungs. Komme immer – wirklich immer – zu spät zu allen möglichen Terminen. Soll ich euch was sagen? Das war schon immer so. Auch vor den Kindern.
Die Zeit rennt eben immer ganz genau gleich schnell ab, egal wie schnell oder langsam wir sie verbringen. Sag ich ja ;-)
___
snowqueen (Das gewünschteste Wunschkind)
Bei drei Kindern, von denen zwei in die Kita und eins in die Schule muss, sowie einer Mutter, die natürlich auch noch bei der Arbeit ankommen sollte, kommt es öfter als mir lieb ist zu Zeitdruck. Da müssen morgens schnell noch das Lieblings-Kuscheltier eingepackt, in das neue Feenbuch geguckt und natürlich kurz vorm Gehen nochmal die Kacka-Windel gewechselt werden, während ich eigentlich schon in voller Montur angezogen bereit stehe und losgehen will… Mein Rezept gegen das Zu-Spät-Kommen ist da recht einfach: Ich zwinge mich, alles extra langsam zu machen, wenn ich merke, die Zeit wird knapp.
Denn wenn ich schnell, schnell alles fertig bekommen möchte, vergesse ich garantiert die Hälfte, oder mein Schnürsenkel reißt plötzlich oder ich verschmiere vor lauter Hektik das AA an Stellen, an die sie nicht hingehören. Also nehme ich den Druck raus und arbeite bewusst langsam. Ich denke nicht an die Uhr, sondern mache das, was zu tun ist, sorgfältig und mit Ruhe. Dann unterlaufen mir keine Fehler und ich komme im Endeffekt schneller los, als bei einem hektischen Aufbruch. Zu spät gekommen sind wir so tatsächlich noch nie!
___
Lena (Schmetterlingsfamilie)
Zeitdruck, ein Problem, dem wohl jeder im Laufe des Lebens hin und wieder begegnet. Manche häufiger und andere weniger, doch grundsätzlich ist es allgemein bekannt.
Meine Familie gehört (wie unser ganzes Dorf übrigens) nicht gerade zur pünktlichen Sorte und es kommt auch mal vor, dass erst zu Beginn des Termins das Haus verlassen wird. Da ich aktuell keinen Führerschein besitze und mit 2 besonderen Kindern somit auf die Fahrdienste meiner Verwandten angewiesen bin, gerate ich häufig in „wir haben keine Zeit mehr verdammt“ Situationen.
Ich nenne zwar in vielen Fällen eine frühere Uhrzeit, doch auch bei mir kommt hin und wieder etwas dazwischen, wodurch es dann mehr als knapp wird. Sei es nun, dass der Elf sich von oben bis unten vollgespuckt hat, der mobile Sauerstofftank sich nicht befüllen lässt, oder Bambina genau dieses eine paar Schuhe anziehen möchte, das gerade nicht auffindbar ist.
Sitzen wir dann endlich im Auto, geht der Blick automatisch zur Uhr und ich gerate innerlich unter großen Zeitdruck. 20 Minuten für 20 Kilometer +Umleitung? Schaffen wir niemals… wie begründe ich es dieses mal? Kann das Auto nicht einfach fliegen? Wieso fährt sie bitte nur 80 auf der Landstraße und wie lange tuckern wir wohl noch dem langsamen Traktor hinterher?
Nach außen bleibe ich vollkommen ruhig, denn all das ändert nun mal nichts an der Situation und lässt uns auch nicht pünktlicher ans Ziel kommen.
Es ist wie mit diesem Text hier; fertig sollte er schon vor Tagen sein und dann kam ich wieder und wieder nicht dazu. Also hoffe ich zum Thema passend einfach nur darauf, noch nicht zu spät dran zu sein ;-)
___
Frau Rabe (das bin ich!)
Für mich gibt es zwei Arten von Zeitdruck. Einmal den unmittelbaren, spontanen, leider beinahe täglich entstehenden: man will aus der Tür, die Kinder zum Kindergarten bringen, da weigert sich erst Pippi, Schuhe anzuziehen, dann diskutiert man mit Michel die Wahl des Matschanzugs, Pippi schreit, weil sie keine Schuhe anlutschen darf, um neun hab ich ein Meeting, es ist viertel nach acht, shitshitshit, das wird alles eng und dann kackt Pippi. Für diese Situationen hab ich keinen Tipp für Sie. Außer vielleicht, dass Kinder immer langsamer werden, je mehr man sie antreibt, wenn man den Tränen nahe ist, sind sie quasi bei der Ultrazeitlupe. Aber wie gesagt: kein Tipp, in solchen Situationen bin ich ein nervöses Huhn mit ultrakurzen Nerven. Und es ist Mist, aber ändern kann ichs auch nicht so mal eben.
Die andere Situation ist sich langfristig aufbauender Zeitdruck. Ich neige nämlich zur Prokrastination. Das heißt, wenn ich in drei Monaten irgendwas abgeben muss, sagen wir mal, ein Abstract, mache ich kurz was dafür und dann lange nix. Also lange so wie 2 Monate lang. Dann ist nur noch ein knapper Monat übrig, aber erst muss noch dies und das und aufräumen müsste man ja auch mal und was ist das hier denn für ein Dings…? Oha, noch eine Woche. Schluck. Das ist dann allerdings der Moment, in dem ich zur Höchstform auflaufe. Der Abstract kriegt Priorität 1, konzentriert arbeite ich daran und sonst an gar nichts, wie so ein Pferd mit Scheuklappen isoliere ich mich komplett und werde immer noch rechtzeitig, wenn auch niemals lange im Vorraus fertig. Ich empfehle diese Vorgehensweise ausdrücklich nicht weiter. Das ist nicht für jeden was. Wenn man zum Beispiel eher der Typ „verschrecktes Kaninchen“ ist, der bei bedrohlich nahen Deadlines keinen klaren Gedanken mehr fassen kann (ich wohne mit so einem zusammen), dann lassen sie das Prokrastinieren besser. Wenn Sie aber wissen, dass Sie’s noch schaffen können und Sie der Druck noch anspornt, dann putzen Sie ruhig mal die Schränke von innen. Das muss ja auch hin und wieder gemacht werden ;) Und sauberer als kurz vor Abgabe von wichtigen Dingen ist es bei mir nie.